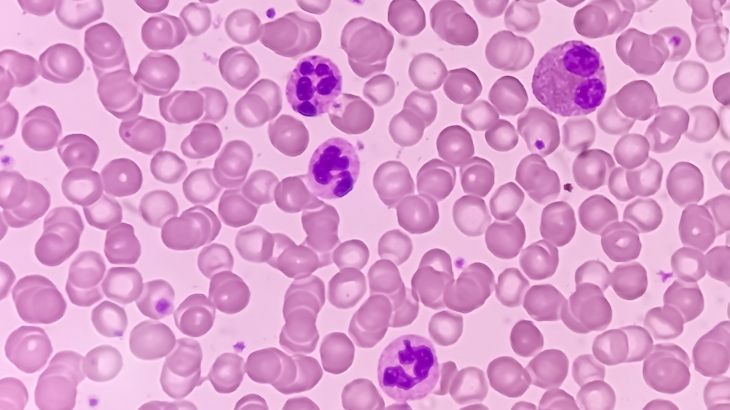

- A'dan Z'ye Sağlık
- >
- İç Hastalıkları (Dahiliye)
- >
- NEU (Nötrofil) Nedir? NEU Düşüklüğü ve Yüksekliği Nedir?
NEU (Nötrofil) Nedir? NEU Düşüklüğü ve Yüksekliği Nedir?
Nötrofiller, bağışıklık sisteminin enfeksiyonlarla savaşında kritik rol oynayan beyaz kan hücreleridir. Normal nötrofil seviyesi mikrolitre başına 2.500-7.000 arasında olmalıdır ve bu seviyelerin üzerinde veya altında olmaları sağlık sorunlarına işaret edebilir. Nötrofil sayısındaki artış enfeksiyon, inflamasyon veya stres gibi durumları gösterirken, düşüklüğü nötropeni olarak adlandırılır ve enfeksiyon riskini artırır.
Nötrofil seviyeleri tam kan sayımı, mutlak nötrofil sayısı ve kemik iliği biyopsisi gibi testlerle ölçülür. Nötropeni tedavisinde antibiyotik, kortikosteroid veya G-CSF tedavileri kullanılabilir.

- NEU (Nötrofil) Nedir? NEU (Nötrofil) Normal Değeri Kaç Olmalıdır? NEU Değerine Nasıl Bakılır? NEU Yüksekliği Nedir? NEU Yüksekliği Neden Olur? Nötrofil Yüksekliği Belirtileri Nelerdir? NEU Düşüklüğü Nedir? NEU Düşüklüğü Neden Olur? Nötrofil Düşüklüğü Belirtileri Nelerdir? Nötrofil Değeri Nasıl Yükselir? Nötrofil Sayısı Nasıl Artar? NEU (Nötrofil) Testleri Nelerdir? NEU (Nötrofil) Hakkında Sıkça Sorulan Sorular
NEU (Nötrofil) Nedir?
NEU (Nötrofil), bağışıklık sistemini koruyan bir çeşit beyaz kan hücresidir. Vücudumuzda üç farklı çeşitte beyaz kan hücresi bulunur. Granülositlerin alt kolu olan nötrofil, diğer beyaz kan hücreleriyle birlikte hareket ederek sağlığımızı enfeksiyonlara ve yaralanmalara karşı korur.
Beyaz kan hücreleri arasında önde gelen bir hücre olan nötrofil, vücudumuza giren bakteri ve virüslere karşı ilk savunmayı yapar. Nötrofiller vücudumuza zarar verecek bakteri ve virüsleri hızlı bir şekilde yok etmeye başlar. Bunu sağlamak için doku onarım sürecini başlatır ve hasarı gidermeye çalışırlar. Nötrofiller bu mücadeleyi verirken vücudumuzda kızarıklık, iltihaplanma ve şişme gibi oluşur.

NEU (Nötrofil) Normal Değeri Kaç Olmalıdır?
Nötrofiller, vücudun enfeksiyonlara karşı ilk savunma hattını oluşturan beyaz kan hücreleridir. Bu nedenle, sağlıklı bir bağışıklık sistemi için nötrofil normal değerinin korunması hayati önem taşır. Ancak, normal kabul edilen değerler yaşa, laboratuvar referans aralıklarına ve hatta bazı bireysel faktörlere göre değişiklik gösterebilir.
Herhangi bir sağlık sorunu olmayan yetişkinlerde nötrofillerin normal aralığı şu şekildedir:
| Durum | NEU Değeri (mikrolitre başına) |
| Normal | 1.500 – 8.000 |
| NEU Düşüklüğü | < 1.500 |
| NEU Yüksekliği | > 8.000 |
8.000'den fazla veya 1.500'ün altında ölçülen nötrofil sayısı, sağlığımızda bir sorun olduğuna işaret eder. Kanımızdaki nötrofil sayısını belirlemek için kan testlerinden yararlanılır. Kan testleri ile belirli bir miktar kandaki nötrofil sayısı ölçülür. Ölçü birimi olaraksa mikrolitre kullanılır.
Yaş gruplarına göre mutlak nötrofil sayısı aşağıdaki gibidir:
| Yaş Grubu | NEU Değeri (mikrolitre başına) |
| Yetişkinler | 1.500 – 8.000 |
| Yeni doğan (0–2 hafta) | 1.600 – 6.750 |
| 2 hafta – 2 ay | 800 – 5.500 |
| 2–6 ay | 1.000 – 7.200 |
| 6 ay – 5 yaş | 1.200 – 8.500 |
| 5–18 yaş | 1.400 – 7.500 |

NEU Değerine Nasıl Bakılır?
NEU (nötrofil) değeri, tam kan sayımı (hemogram) testi ile belirlenir. Bu test, hastaneler ve laboratuvarlarda uygulanan en yaygın kan tahlillerinden biridir.
Test sırasında kol damarından alınan bir tüp kan örneği, laboratuvar ortamında otomatik analiz cihazlarında değerlendirilir. Sonuçlar içerisinde NEU değeri, hem mutlak nötrofil sayısı (x10³/µL) olarak hem de nötrofillerin toplam beyaz kan hücreleri içindeki yüzdesi şeklinde yer alır.
NEU değeri, enfeksiyonlar, bağışıklık sistemi hastalıkları ve bazı kronik rahatsızlıkların tanı ve takibinde önemli bir parametredir. Doktorlar, hastanın genel sağlık durumu, şikayetleri ve diğer kan parametreleriyle birlikte NEU değerini yorumlayarak tanıya ulaşır.
NEU Yüksekliği Nedir?
Neu yüksekliği, kandaki nötrofil miktarının fazla olması durumudur. NEU, yani nötrofil, beyaz kan hücrelerinin bir türüdür ve bağışıklık sisteminizin ön saflarında yer alır. Bakteri, virüs ve mantar gibi mikroplara karşı savaşarak sizi korurlar. Dolayısıyla, NEU yüksekliği, vücudunuzun bu savaşçıları daha fazla üreterek enfeksiyona karşı daha güçlü bir savunma oluşturduğunu gösterir.
Ancak, her zaman enfeksiyon anlamına gelmez. Stres, yoğun egzersiz, bazı ilaçlar, sigara kullanımı ve hatta hamilelik bile NEU seviyelerini geçici olarak yükseltebilir. Nadir durumlarda, kemik iliği hastalıkları veya bazı kanser türleri de sürekli yüksek NEU değerlerine neden olabilir.
Bu nedenle, sürekli veya açıklanamayan bir NEU yüksekliği durumunda mutlaka doktorunuza başvurmanız önemlidir.
NEU Yüksekliği Neden Olur?
Nötrofil yüksekliği, vücudumuzun bir sağlık sorunu ile mücadele ettiğini ortaya koyar. Kanda 7.000’den fazla nötrofil sayısının ölçülmesi, nötrofil yüksekliği yaşandığı anlamına gelir. Bu durum genellikle vücutta bir enfeksiyon, iltihap veya stres olduğunu gösterir. Bazı ilaçlar, yaralanmalar ve bazı kanser türleri kanda neu yüksekliğine sebep olabilir.
Neu yüksekliği nedenleri şunlardır:
- Enfeksiyonlar,
- Enflamasyon,
- Yaralanma,
- Bazı lösemi türleri,
- Bazı akciğer tümörleri,
- Bazı ilaçlara karşı gelişen reaksiyonlar,
- Mantar, bakteri ve parazit enfeksiyonları,
- Stres,
- Sigara ve diğer tütün türevlerinin tüketimi.
Kemik Kırılması ve Yanık Vakaları Sonrası Neu Yüksekliği
Kemik kırılması ya da önemli yanık vakalarında vücudun yüksek miktarda nötrofil üretmesi bağışıklık sisteminin harekete geçtiği anlamına gelir ve böyle durumlarda hasarın giderilmesinden sonra nötrofil sayısı normale dönmelidir.
Yaralanma Sonrası Neu Yüksekliği
Yaralanmanın iyileştirilmesinden sonra nötrofil sayısının normal değerlerine inmemesi, yine bir sağlık sorunu varlığına işaret edebilir.
Nötrofil Yüksekliği Belirtileri Nelerdir?
Neu yüksekliği, sıklıkla bakteriyel enfeksiyonlar sırasında yaşanır. Bunun nedeni ise bakteri kaynaklı enfeksiyonlar sırasında henüz gelişimini tam olarak tamamlamamış nötrofillerin kemik iliğinden ayrılarak hastalıkla mücadele etmek için kan dolaşım sistemine katılmasıdır.
Öte yandan, nötrofil yüksekliği genellikle vücutta bir enfeksiyon, iltihap veya stres olduğunu gösterir. Neu yüksekliği nedenleri arasında enfeksiyonlar, iltihaplar, stres, bazı ilaçlar, yaralanmalar ve bazı kanser türleri sayılabilir.
Neu yüksekliğinin belirtileri arasında ateş, halsizlik, titreme ve terleme gibi genel enfeksiyon belirtileri bulunabilir. Altta yatan neden tedavi edilerek nötrofil seviyeleri normale dönebilir. Bazı durumlarda, ilaç tedavisi gerekebilir. Genellikle altta yatan bir enfeksiyon veya iltihap nedeniyle yükselir, bu nedenle tedavi bu duruma yönelik olmalıdır.
Nötrofil yüksekliği belirtileri şunlardır:
- Yorgunluk ve güçsüzlük hissi,
- 38 derece ve üzeri ateş,
- Baş dönmesi veya bayılma hissi,
- Tekrarlayan enfeksiyonlar,
- İyileşmeyen yaralar,
- Şişmiş veya ağrılı eklemler.
Nötrofil Nasıl Düşürülür?
Bir tür beyaz kan hücresi olan nötrofillerin artması, farklı nedenlerden kaynaklanır. Bu nedenlerin tespitinin ardından belirlenecek sağlık sorunlarının tedavisi ile netrofil seviyesi düşer. Nötrofil yükselmesinin ardında sıklıkla enfeksiyona dayalı rahatsızlıklar bulunur. Enfeksiyon tedavisinde ise antibiyotik kullanımı tercih edilir ve sorun enfeksiyon kaynaklıysa, antibiyotik tedavisinin ardından nötrofil sayısı düşer.
NEU Düşüklüğü Nedir?
Nötropeni olarak da bilinen NEU düşüklüğü, kandaki nötrofil sayısının normalin altında olması durumudur. Bu durum, bağışıklık sistemini zayıflatarak enfeksiyonlara karşı daha savunmasız hale getirir.
Kemik iliği sorunları, bazı ilaçlar, enfeksiyonlar ve otoimmün hastalıklar gibi çeşitli faktörler NEU düşüklüğüne yol açabilir.

NEU Düşüklüğü Neden Olur?
Nötrofil düşüklüğü, yani nötropeni, kandaki nötrofil sayısının normalin altında olması durumudur. Bağışıklık sistemini zayıflatarak enfeksiyonlara karşı daha savunmasız hale getiren bir durumdur. Kemik iliği sorunları, bazı ilaçlar, enfeksiyonlar ve otoimmün hastalıklar gibi çeşitli faktörler nötrofil düşüklüğüne yol açabilir.
Özellikle bebeklerde nötrofil düşüklüğü, bağışıklık sisteminin henüz tam gelişmemiş olmasından kaynaklanabilir. Nötrofil lenfosit oranı, farklı beyaz kan hücresi tipleri arasındaki dengeyi değerlendirmek için kullanılır ve bazı hastalıkların teşhisinde yardımcı olabilir. Nötrofil düşüklüğüne (nötrofil yüzdesi düşüklüğü) tıp literatüründe nötropeni adı verilir.
Eğer nötrofil düşüklüğünüz varsa tekrar eden enfeksiyonlar ve vücudunuzda şişmeler yaşayabilirsiniz. Nötrofil düşüklüğünde, kemik iliği yeterince nötrofil üretemeden vücudunuz nötrofilleri yok eder.
Genetik Geçiş
Nötrofil düşüklüğüne neden olan genetik sorunlar anne ve babadan çocuklarına aktarılabilir.
Enfeksiyonlar
Virüs, bakteri ve parazit sebepli enfeksiyonlar nötrofil düşüklüğüne yol açabilir. Aynı şekilde HIV, hepatit, tüberküloz, sepsis ve Lyme hastalığı da nötrofil düşüklüğünün oluşmasına sebep olabilir.
Kanser
Kanser, lösemi ve lenfoma dahil diğer kan ve/veya kemik iliği hastalıkları vücudunuzun ihtiyaç duyulduğu kadar sağlıklı beyaz kan hücresi üretmesine mani olur ve nötrofil düşüklüğüne yol açabilir.
Kullanılan Bazı İlaçlar
Kanser tedavisinde kullanılan kemoterapi ve radyasyon tedavisi, nötrofil seviyesinin düşmesine neden olabilir. Kanser tedavisinde kullanılmayan kimi ilaçlar da düşük nötrofil seviyeleri yaratabilir.
Beslenme Yetersizlikleri
B12 vitamini, folat veya bakır gibi vitamin ve minerallerin vücudunuzda yeterince bulunmaması nötrofil düşüklüğü yapabilir.
Bağışıklık Sistemi Sorunları
Bazı bağışıklık sistemi sorunlarında vücudunuz sağlıklı nötrofilleri yok edebilir. Bu sorunlar arasında Crohn hastalığı, lupus ve romatoid artrit bulunur.
Nötrofil Düşüklüğü Belirtileri Nelerdir?
Nötrofil düşüklüğü tek başına herhangi bir belirti göstermez ancak nötropeninin kökeninde yer alan enfeksiyonlar bazı belirtilere neden olabilir. Tekrarlanan enfeksiyonlar aynı zamanda nötrofil düşüklüğü belirtisi olarak değerlendirilir.
Belirtiler şunları içerebilir:
- Ateş (ateşli nötropeni),
- Halsizlik,
- Farenjit,
- Lenf düğümlerinde şişlik,
- Ağzı veya anüs bölgesinde yaralar,
- Enfeksiyon bölgesinde ağrı, şişlik ve döküntü,
- İshal,
- İdrar yapma sırasında yanma hissi,
- Sık idrara çıkma,
- İdrar yaparken ağrı.
Hafif bir nötrofil düşüklüğü halinde vücudunuz enfeksiyonlarla savaşacak kadar kadar nötrofil barındırabilir ve bu nedenle herhangi bir yakınma gelişmeyebilir ya da çok hafif belirtiler olduğu için yakınmaları fark etmeyebilirsiniz.
Nötrofil Değeri Nasıl Yükselir?
Bazı nötrofil düşüklükleri için tedaviye ihtiyaç duyulmayabilir. Diğer tedavi yöntemleri ise nedene göre değişir bu tedavilerin arasında şunlar bulunur.
Antibiyotik Tedavisi
Febril nötropeni yani ateşle birlikte gelişen nötrofil düşüklüğü yaşıyorsanız, nötrofil değerinizin yükselmesi için doktorunuz tarafından antibiyotik reçete edilir.
Kortikosteroidler
Bağışıklık sistemine dayalı rahatsızlıklarda, doktor önerisi ile kortikosteroid içeren ilaçlar kullanılır. Bu ilaçlar yardımıyla nötrofillerin tahrip edilmesine sebep olan bağışıklık sistemi tepkisini giderilir.
Granülosit Koloni Uyarıcı Faktör (G-CSF)
Doktorunuz ayrıca kemik iliğinizde beyaz kan hücrelerinin üretimini arttıran ilaçları kullanmanızı isteyebilir. Kemoterapi tedavisi görüyorsanız yüksek ihtimalle G-CSF kullanımı önerilebilir. Kullandığınız herhangi bir ilaç nötrofil düşüklüğüne neden oluyorsa doktorunuz sizden bu ilacın miktarını ya da kullanım sıklığını azaltmanızı veya kullanmayı bırakmanızı isteyebilir.
Nötrofil Sayısı Nasıl Artar?
Nötrofil sayısında yaşanan düşüklük doktor önerileriyle giderilmelidir. Doktorunuz nötrofil sayınızı arttırmak için şu önerilerde bulunabilir:
- Kanser tedavisinde düzenlemeler: Eğer kanser için kemoterapi tedavisi görüyorsanız doktorunuz kemoterapi dozunu azaltabilir ya da sıklığında değişikliğe gidebilir,
- Beyaz kan hücresi takviyesi: Dışarıdan beyaz kan hücresi transferi önerebilir,
- Kullanılan ilaçların kontrolü: Sayının düşmesine neden olan etken kullandığınız bir ilaçtan kaynaklanıyorsa ilaç kullanımını kesebilir, dozunu azaltabilir ya da sıklığını düşürebilir,
- Antibiyotik kullanımı: Beyaz kan hücrelerinin artmasına katkıda bulunmak için antibiyotik ya da başka ilaçların kullanımını önerebilir.
Nötrofil Yükselten Yiyecekler
Nötrofil sayınız düşükse doktor tavsiyesi ile bağışıklık seviyenizi arttırmak için bağışıklık A, B, C, E vitaminleri, karotenler, demir, çinko, selenyum desteği gerekebilir. Ayrıca Omega-3 ve antioksidan barındıran besinler yiyerek nötrofil sayısını artırmaya katkıda bulunabilirsiniz.
Nötrofil yükselten yiyecekler şunlardır:
- Protein açısından zengin besinler
- C vitamini içeren meyve ve sebzeler
- Çinko ve selenyum gibi mineraller bakımından zengin gıdalar
Ancak, herhangi bir diyet değişikliği yapmadan önce doktorunuza danışmanız önemlidir.
NEU (Nötrofil) Testleri Nelerdir?
Nötrofil (NEU) seviyelerini değerlendirmek, vücudun enfeksiyonlarla mücadele kapasitesini anlamak için kritik öneme sahiptir.
Bu amaçla başvurulan temel testler şunlardır:
- Tam Kan Sayımı (Hemogram): Kan dolaşımındaki tüm hücre tiplerini sayan ve nötrofil oranını belirleyen Tam Kan Sayımı (Hemogram).
- Mutlak Nötrofil Sayısı (MNS): Diğer bir yöntem ise, vücuttaki aktif nötrofil miktarını kesin olarak belirleyen Mutlak Nötrofil Sayısı (MNS) testidir. Özellikle nötropeni (düşük nötrofil sayısı) şüphesi veya bağışıklık sistemini baskılayan tedaviler sırasında enfeksiyon riskini değerlendirmede kullanılır.
- Kemik İliği Biyopsisi: Nadir durumlarda, kan hücresi üretiminin kökenine inmek ve olası anormallikleri tespit etmek için Kemik İliği Biyopsisi gerekebilir. Bu test, kemik iliğinden alınan bir örneğin mikroskop altında incelenmesini içerir. Bu, beyaz kan hücrelerinin bir türü olan nötrofillerin sayısını ölçen bir testtir.
Tam Kan Sayımı (Hemogram)
Tam Kan Sayımı, genel sağlık durumunun değerlendirilmesinde sıklıkla başvurulan bir kan testidir. Bu test, kandaki kırmızı kan hücreleri, beyaz kan hücreleri ve trombositler dahil olmak üzere tüm hücre tiplerinin sayısını ve oranını ölçer. Nötrofiller, beyaz kan hücrelerinin bir alt tipi olarak, bu testte özel bir öneme sahiptir çünkü vücudun enfeksiyonlarla savaşma yeteneğini doğrudan etkilerler.
Hemogram sonuçları, nötrofil seviyelerindeki anormallikleri (nötropeni veya nötrophili) ortaya çıkararak, altta yatan enfeksiyonlar, inflamasyonlar veya daha ciddi hastalıkların varlığına dair ipuçları sağlayabilir. Ayrıca down sendromu olan bireylerde, bağışıklık sistemi ile ilgili sorunlar nedeniyle nötrofil seviyeleri düşük olabilir, bu da enfeksiyon riskini artırabilir. aynı zamanda kalp krizi sonrasında, vücut bir iltihaplanma tepkisi verebilir ve bu durum, nötrofil seviyelerinde geçici bir artışa yol açabilir.
Mutlak Nötrofil Sayısı
Mutlak Nötrofil Sayısı (MNS), vücutta dolaşan aktif nötrofil sayısını kesin olarak belirlemek için yapılan bir hesaplamadır. Hemogram sonuçlarındaki nötrofil yüzdesi ve toplam beyaz kan hücresi sayısı kullanılarak elde edilir. MNS, özellikle bağışıklık sistemi zayıflamış kişilerde enfeksiyon riskini değerlendirmek veya kemoterapi gibi tedavilerin etkilerini izlemek için kritik bir öneme sahiptir.
Düşük MNS, enfeksiyonlara karşı artan duyarlılığı gösterirken, yüksek MNS genellikle vücutta devam eden bir enfeksiyon veya inflamatuar sürecin işaretidir.
Kemik İliği Biyopsisi
Kemik iliği biyopsisi, diğer testlerin yetersiz kaldığı veya daha detaylı bir inceleme gerektiren durumlarda başvurulan bir işlemdir. Bu prosedür, kalça kemiğinden veya göğüs kemiğinden küçük bir miktar kemik iliği örneği alınmasını ve bu örneğin mikroskop altında incelenmesini içerir.
Kemik iliği, kan hücrelerinin üretildiği yer olduğundan, biyopsi sonuçları nötrofil üretimindeki herhangi bir anormalliği, kemik iliği hastalıklarını veya enfeksiyonları ortaya çıkarabilir. Bu test, özellikle nötropeni veya diğer kan hücresi anormalliklerinin nedenini belirlemek için kullanılır ve tanı ve tedavi planlamasında önemli bir rol oynar.
NEU (Nötrofil) Hakkında Sıkça Sorulan Sorular
Nötrofil Yükselten Yiyecekler Nelerdir?
C vitamini, çinko ve E vitamini açısından zengin besinler, bağışıklık sistemini güçlendirerek nötrofil üretimini destekleyebilir..
Bebeklerde Nötrofil Düşüklüğü Nasıl Olur?
Bebeklerde nötrofil düşüklüğü (nötropeni); enfeksiyonlar, bazı ilaçlar, genetik bozukluklar veya anne karnındaki sorunlar nedeniyle ortaya çıkabilir.
NEU Düşüklüğü Ne Anlama Gelir?
Nötrofil düşüklüğü (nötropeni), vücudun enfeksiyonlarla savaşma yeteneğinin azaldığını gösterir.
NEU Yüksekliği Tehlikeli midir?
Nötrofil yüksekliği (nötrophili), genellikle vücutta bir enfeksiyon, iltihap veya stres olduğunu gösterir. Çoğu durumda geçicidir ve tedavi gerektirmez. Ancak, çok yüksek seviyeler veya uzun süreli nötrophili, altta yatan bir sağlık sorununa işaret edebilir.
NEU Değerlerimi Nasıl Normal Aralığa Getirebilirim?
Nötrofil değerlerinizi normal aralığa getirmek için altta yatan nedeni tedavi etmek önemlidir.
Nötrofil Sayısı Nasıl Düşürülür?
Nötrofil sayısını düşürmek için genellikle altta yatan neden tedavi edilir. Örneğin, enfeksiyon kontrol altına alındığında veya ilaçlar ayarlandığında nötrofil sayısı normale dönebilir.
Nötrofil Yüksekliği Belirtileri Nelerdir?
Nötrofil yüksekliği genellikle belirti göstermez. Ancak, altta yatan enfeksiyon veya iltihapa bağlı olarak ateş, halsizlik, terleme, titreme, ağrı veya ciltte kızarıklık gibi belirtiler görülebilir.
Nötrofil Düşüklüğü Belirtileri Nelerdir?
Nötrofil düşüklüğü; sık enfeksiyonlara, ateş, ağız yaraları, boğaz ağrısı, cilt enfeksiyonları ve yorgunluk gibi belirtilere neden olabilir.
Nötrofil Değeri Nasıl Yükselir?
Nötrofil değeri, enfeksiyon veya iltihap gibi durumlarda vücudun doğal savunma mekanizması olarak yükselir. Ayrıca, bazı ilaçlar, stres veya fiziksel aktivite de nötrofil değerini geçici olarak artırabilir.
Kanda Neu% Kaç Olmalıdır?
Kanda normal nötrofil yüzdesi (%Neu), genellikle %40 ile %60 arasındadır. Ancak, bu değerler laboratuvarlar arasında ve yaşa göre biraz farklılık gösterebilir.
Nötrofil Nedir?
Nötrofiller, bağışıklık sisteminin bir parçası olan, bakteri ve mantar enfeksiyonlarıyla savaşan beyaz kan hücreleridir. Kemik iliğinde üretilir ve kan dolaşımında görev yapar.
Nötrofil Yüksekliği Nedir?
Nötrofil yüksekliği (nötrofili), genellikle enfeksiyon, iltihap veya stres gibi durumlarda kandaki nötrofil sayısının normalin üzerine çıkmasıdır. Bazı ilaçlar ve kronik hastalıklar da bu artışa neden olabilir.
Nötrofil Düşüklüğü Nedir?
Nötrofil düşüklüğü (nötropeni), kandaki nötrofil sayısının normal seviyenin altına inmesidir. Bu durum bağışıklık sistemini zayıflatarak enfeksiyon riskini artırır.
Tam Kan Sayımı Neu Nedir?
Tam kan sayımında NEU, nötrofilleri ifade eden laboratuvar kısaltmasıdır. Nötrofil sayısını ya mutlak değer (NEU#) ya da yüzde oranı (NEU%) şeklinde gösterir.
Kanda Neu Yüksekliği Nedir?
Kanda NEU yüksekliği, nötrofillerin normalden fazla olması durumudur. Bu genellikle akut enfeksiyonlar, iltihabi hastalıklar veya stres yanıtıyla ilişkilidir.
Neu Kan Değeri Nedir?
NEU kan değeri, kanda bulunan nötrofillerin sayısını veya yüzdesini gösteren laboratuvar ölçümüdür. Sağlıklı bireylerde bu değer belirli bir referans aralığında seyreder.
Bize Ulaşın
Her türlü soru, görüş ve önerileriniz için aşağıdaki formdan bizimle iletişime geçebilirsiniz. Talebiniz doğrultusunda Çağrı Merkezi yetkililerimiz size en kısa sürede dönüş yapacaklardır.





